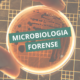

Coleta sanguínea em pesquisas clínicas
A coleta sanguínea em pesquisas clínicas é uma etapa essencial para garantir a confiabilidade dos dados laboratoriais, uma vez que envolve procedimentos que podem impactar diretamente a qualidade das amostras e dos resultados obtidos. Entre os diversos fatores envolvidos, a validação dos métodos de coleta sanguínea ocupa um papel central, uma vez que pequenas variações nesse procedimento podem comprometer significativamente a integridade da amostra e, consequentemente, a interpretação dos resultados.
Diferentemente da rotina assistencial, em que protocolos já estão amplamente estabelecidos, os estudos clínicos frequentemente exigem adaptações específicas nos métodos de coleta, seja pela natureza dos analitos investigados, seja pelas condições experimentais impostas. Nesse contexto, a validação torna-se essencial para assegurar que o método empregado seja adequado, reprodutível e capaz de gerar dados confiáveis.
O que significa validar um método de coleta sanguínea?
A validação de um método consiste na comprovação, por meio de evidências documentadas, de que um determinado procedimento é capaz de produzir resultados consistentes e apropriados para o objetivo proposto. No caso da coleta sanguínea, isso envolve a avaliação de todas as variáveis que possam impactar a qualidade da amostra.
Esse processo inclui desde a escolha do tipo de tubo e anticoagulante até as condições de transporte e armazenamento, passando por fatores como tempo de garroteamento, técnica de punção e manipulação da amostra após a coleta.
Mais do que uma formalidade metodológica, a validação representa um mecanismo de controle de qualidade essencial para reduzir vieses e garantir a integridade científica do estudo.
Principais parâmetros avaliados na validação
A validação de métodos de coleta sanguínea em pesquisas clínicas deve considerar múltiplos parâmetros, que, em conjunto, asseguram a robustez do processo:
Reprodutibilidade
Refere-se à capacidade do método de gerar resultados consistentes quando aplicado em diferentes momentos, por diferentes profissionais ou em diferentes locais. A variabilidade na coleta pode introduzir distorções significativas nos dados laboratoriais.
Estabilidade dos analitos
Avalia se os componentes de interesse permanecem estáveis desde o momento da coleta até a análise. Fatores como temperatura, tempo de armazenamento e tipo de recipiente podem influenciar diretamente essa estabilidade.
Interferências pré-analíticas
Incluem eventos como hemólise, lipemia e contaminação, que podem alterar os resultados laboratoriais. A validação deve identificar e minimizar essas interferências.
Adequação ao objetivo do estudo
Nem todo método de coleta é adequado para todos os tipos de análise. Estudos envolvendo biomarcadores moleculares, por exemplo, exigem cuidados específicos para evitar degradação de DNA ou RNA.
Etapas do processo de validação
A validação de métodos de coleta sanguínea segue uma abordagem sistemática, geralmente estruturada em etapas bem definidas:
1. Planejamento
Nesta fase, são definidos os objetivos do estudo, os analitos de interesse e os requisitos técnicos da coleta. Também são selecionados os materiais e equipamentos a serem utilizados.
2. Testes piloto
Consistem na aplicação inicial do método em pequena escala, permitindo identificar possíveis falhas ou fontes de variabilidade antes da implementação definitiva.
3. Análise de desempenho
Os dados obtidos são avaliados quanto à precisão, estabilidade e presença de interferências. Ajustes no protocolo podem ser necessários nesta etapa.
4. Padronização
Uma vez validado, o método deve ser documentado de forma detalhada, garantindo sua aplicação uniforme ao longo de todo o estudo.
5. Monitoramento contínuo
Mesmo após a validação, é fundamental manter o acompanhamento da qualidade da coleta, por meio de indicadores e auditorias internas.
Desafios na validação em pesquisas clínicas
A validação de métodos de coleta sanguínea não está isenta de desafios. Entre os principais, destacam-se:
- Variabilidade biológica dos participantes, que pode influenciar parâmetros laboratoriais independentemente da coleta
- Diferenças entre operadores, mesmo quando treinados
- Limitações logísticas, especialmente em estudos multicêntricos
- Necessidade de adaptação a novos biomarcadores, muitas vezes ainda pouco padronizados
Esses fatores reforçam a importância de protocolos robustos e de treinamento contínuo das equipes envolvidas.
Impacto na qualidade dos dados e na tomada de decisão
A ausência de validação adequada pode resultar em dados inconsistentes, comprometendo análises estatísticas e levando a conclusões equivocadas. Em pesquisas clínicas, isso não apenas afeta a qualidade científica do estudo, mas também pode impactar diretamente decisões relacionadas à segurança e eficácia de intervenções terapêuticas.
Por outro lado, métodos de coleta bem validados contribuem para a geração de dados mais confiáveis, fortalecendo a evidência científica e aumentando a credibilidade dos resultados obtidos.
A validação de métodos de coleta sanguínea é um componente essencial na condução de pesquisas clínicas de alta qualidade. Ao garantir que a fase pré-analítica esteja sob controle rigoroso, torna-se possível minimizar variabilidades, reduzir interferências e assegurar que os dados laboratoriais reflitam, de fato, as condições biológicas investigadas.
Nesse cenário, a atenção aos detalhes, o rigor metodológico e a padronização dos processos não são apenas boas práticas, mas requisitos indispensáveis para a produção de conhecimento científico confiável.
Quer dominar a coleta sanguínea com segurança e precisão? O Coletores de Elite reúne tudo o que é essencial para reduzir erros e elevar a qualidade dos resultados. Garanta sua vaga